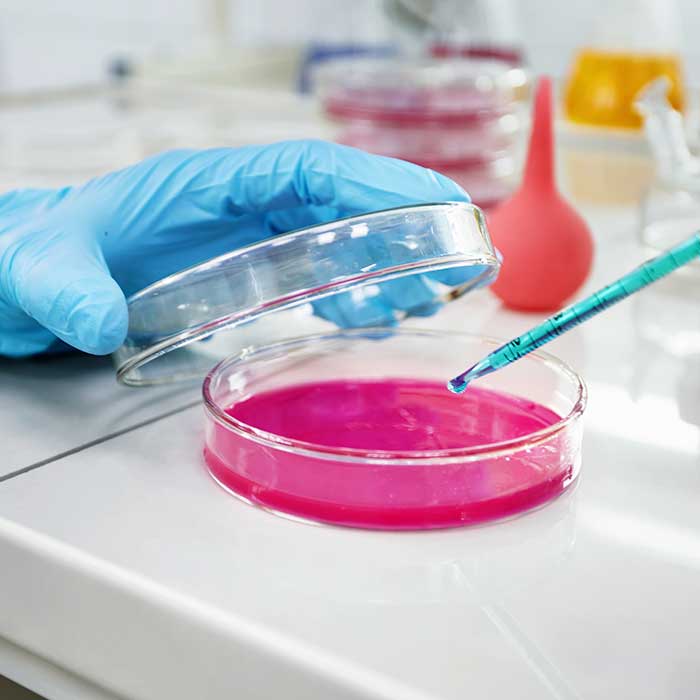

Why Advik Colors
Advik Color Apart from the Competition

01
Quality Assurance
At Advik Colors, quality is not just a standard; it’s a promise. Every batch we produce undergoes rigorous quality control processes at multiple stages—from raw material selection to the final packaging.
Our skilled team of experts ensures that every product aligns with global industry standards, backed by thorough inspections and detailed quality reports. We perform random spot checks on all shipments to maintain high levels of consistency. As an ISO 9001:2015 certified company, our commitment to excellence means you receive only the best synthetic colors, every time.

02
Matchless Variety
At Advik Colors, we offer an extensive range of synthetic food colors, cosmetic pigments, pharma & nutraceutical colors, and personal care & homecare colors. With a wide spectrum of shades, formulations, and applications, our products cater to the unique needs and preferences of different industries.
Whether you’re looking for vibrant food colors or precise pharma-grade pigments, our diverse selection ensures we can meet the exact requirements of global customers, helping you stand out in your market.

03
Excellent Production Capacity
Our robust in-house production capabilities allow us to handle projects of any size with precision. This results in quicker turnaround times and a reliable supply chain, ensuring our international partners receive their orders on time and without hassle.
At Advik Colors, we understand the importance of timely delivery, giving you the confidence that your demands will be met efficiently and consistently.

04
Premium Quality at Competitive Prices
At Advik Colors, we believe that superior quality should be affordable for all. Through our advanced production processes and cost-efficient techniques, we provide top-tier synthetic colors at highly competitive rates. This means our clients enjoy exceptional value, receiving premium-quality products without compromising on their budget.
We’re committed to offering the best solutions that combine quality with affordability.

05
Long-Term Partnership Focus
At Advik Colors, we are dedicated to fostering lasting relationships with our clients. Our business philosophy revolves around mutual growth and long-term success.By deeply understanding your unique requirements and consistently providing exceptional products and services, we strive to be your trusted partner for the future.
Together, we aim to build a foundation of success that lasts for years to come.

06
Boundless Product Range
At Advik Colors, our dedication to innovation drives us to continuously expand our product portfolio with cutting-edge trends and advanced technologies. This boundless variety ensures you always have access to fresh and unique color solutions, keeping you ahead in your industry.
Whether it’s food colors, cosmetic pigments, or pharma-grade dyes, our diverse offerings give you a competitive edge in your market.

07
Try Before You Commit
At Advik Colors, we believe in complete transparency. That’s why we offer free samples, allowing you to experience the vibrant quality and performance of our colors firsthand before making a purchase.
This helps build trust and ensures that you are confident in the superior quality of our products, giving you peace of mind with every order.

08
Trust Through Transparency
At Advik Colors, we encourage you to visit our manufacturing facilities and witness our operations and commitment to quality firsthand. This openness reinforces our dedication to upholding the highest standards and fosters long-term relationships with our clients.
We believe that transparency is key to building trust and ensuring you feel confident in choosing us as your partner.

09
Tailored Packaging Solutions
At Advik Colors, our custom packaging solutions are crafted to meet the diverse needs of our clients. Designed for various sizes, our high-quality packaging ensures a robust and stable platform, making storage and stacking effortless.
Each package is wrapped in waterproof and dustproof materials to safeguard against damage, ensuring your products arrive in pristine condition.

10
Timely Delivery
At Advik Colors, we meticulously plan every aspect of our delivery process to eliminate delays. Our products are dispatched on the earliest available shipments, and we ensure that all customs documentation is prepared according to each country’s specific requirements for seamless transitions.
We ship consignments with letters of credit, streamlining document processing between the shipper’s bank and the consignee’s bank in accordance with Incoterms 2000. With our commitment to on-time delivery, you can trust that your projects will remain on schedule.
11
Innovative Product Development
At Advik Colors, we stay at the forefront of industry trends by leveraging global market insights to inspire our product innovation. Utilizing the latest technology and a diverse range of materials, we develop unique synthetic colors and pigments that cater to both current and emerging market demands.
Our commitment to innovation ensures that you always have access to cutting-edge products that keep you competitive in your industry.

12
Effortless Purchasing Experience
At Advik Colors, we recognize the importance of a seamless buying process. Our streamlined purchasing experience makes it simple for you to access the information you need and place your orders with confidence.
We prioritize clear communication and dedicated support at every step of your purchasing journey, ensuring that your experience is both efficient and enjoyable.

13
Outstanding After-Sales Support
At Advik Colors, our dedication to your success goes beyond the sale. We provide outstanding after-sales support, ensuring that we’re available to address any questions or concerns you may have.
Our dedicated team is committed to your complete satisfaction, helping you maximize the value of our products long after your purchase.

14
Swift and Responsive Service
At Advik Colors, we value your time and understand the urgency of your needs. You can count on us for quick responses to every inquiry or concern, ensuring a smooth and stress-free experience.
Our responsive service is tailored to effectively support your business needs, allowing you to focus on what matters most.

15
Exclusive Regional Dealership Opportunities
At Advik Colors, we provide exclusive regional dealership opportunities, enabling you to become the sole representative of our high-quality products in your area. This exclusivity empowers you to maximize your market potential and gain a significant competitive advantage.
Join us and tap into the vast possibilities of our innovative product offerings.

16
Robust Indian Dealership Network
Advik Colors boasts a comprehensive dealership network that spans every state in India. This extensive presence guarantees that our premium quality synthetic food colors and pigments are readily accessible, no matter where your business is located.
With us, you can be confident in a reliable supply chain that meets your needs.

17
In-Depth Product Training
At Advik Colors, we offer in-depth training for your sales and distribution teams to ensure they fully understand the features and benefits of our products.
This comprehensive training equips your team with the knowledge they need to effectively promote our synthetic food colors and pigments, enhancing their sales capabilities and driving your business growth.

18
Personalized Account Management
At Advik Colors, we assign a dedicated account manager to each client, serving as your single point of contact for all inquiries and orders. This personalized approach ensures you receive prompt, tailored support, making your experience with us seamless and efficient.
We are committed to understanding your unique needs and providing the assistance you require to succeed.
